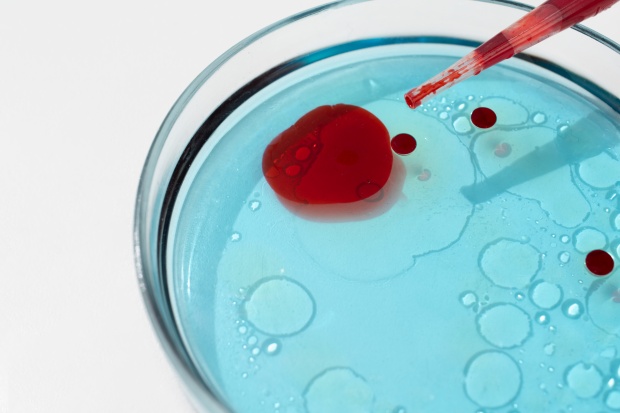
Изследване при намален брой на еритроцити Изследване при намален брой на еритроцити

Намален брой на еритроцитите
› Какво представляват еритроцитите
› По-чести причини за възникване
Въведение
Намален брой на еритроцитите представлява състояние, при което се установяват понижен брой червени кръвни клетки в кръвния серум. Състоянието се означава още с медицинския термин еритроцитопения. Референтните стойности на еритроцитите варират са в границите 4.0-5.9 х1012/L при мъже и 3.8-5.2 х1012/L при жени. Ниският брой на еритроцити обикновено е белег на анемичен синдром, който може да има различна етиология - от дефицит на желязо, витамин B12 или фолиева киселина до хронични заболявания и увреждания на костния мозък.
Червените кръвни клетки (еритроцити) имат основната роля да пренасят кислород до всички части на тялото. Тази способност зависи от количеството хемоглобин - белтъкът, който свързва и транспортира кислорода. Когато нивата на хемоглобина са понижени, снабдяването на тъканите с кислород се затруднява. Намаленият брой еритроцити е характерен за анемията - състояние, при което кръвта не може да осигури достатъчно кислород за нормалното функциониране на органите и тъканите.
» Повече информация по темата: Анемия
Намаленият брой на еритроцитите може да се дължи на:
- Болести на кръвта, кръвотворните органи и отделни нарушения, включващи имунния механизъм - хемолитична анемия.
- Болести на ендокринната система, разстройства на храненето и на обмяната на веществата - дефицит на желязо, дефицит на витамин B12, дефицит на фолиева киселина, белтъчен дефицит, недохранване.
- Болести на храносмилателната система - цьолиакия, гастрит, малабсорбция на хранителни вещества, резекция на стомаха, хиперспленизъм.
- Болести на органите на кръвообращението - хронична сърдечна недостатъчност.
- Травми, отравяния и други външни въздействия - остра/хронична кръвозагуба, злоупотреба с алкохол, интоксикация с тежки метали.
- Вродени аномалии и генетични нарушения - генетични нарушения в синтеза на хемоглобин.
- Симптоми, признаци и отклонения от нормата - аномалия на еритроцитите (пойкилоцитоза, сфероцитоза, дрепаноцитоза, микроцитоза).
- Новообразувания - миелодиспластичен синдром, левкемия, метастази в костния мозък.
Какво представляват еритроцитите

Еритроцитите, познати още като червени кръвни клетки, са най-многобройният вид клетки в кръвта. Те се образуват в костния мозък от стволови клетки като процесът се нарича еритропоеза. Производството на еритроцитите се стимулира от хормона еритропоетин, който се синтезира в бъбреците.
Зрелият еритроцит има двойно вдлъбната (биконкавна) форма, която увеличава повърхността му многократно и улеснява обмена на газове. Основната функция на еритроцитите е транспортът на кислород до тъканите и връщането на въглеродния диоксид към белите дробове, където се отделя при издишване.
Животът на еритроцитите е приблизително 100-120 дни. След това те се подлагат на хемолиза основно в слезката и черния дроб. Балансът между образуване и разрушаване на еритроцитите е от съществено значение за поддържането на нормален брой червени кръвни клетки.
Референтни стойности
Броят на еритроцитите в кръвта зависи от пола, възрастта и използваните методи за анализ във всяка лаборатория. Поради това е важно резултатите винаги да се интерпретират спрямо референтните стойности, посочени от конкретната лаборатория.
- Мъже: 4.0 - 5.9 х 1012/L
- Жени: 3.8 - 5.2 х 1012/L
- Деца: варират според възрастта. В първите месеци след раждането броят на еритроцитите физиологично намалява, а в детска и юношеска възраст постепенно се доближава до стойностите при възрастните.
По-чести причини за възникване
Дефицит на желязо
Желязото е ключов микроелемент, необходим за синтеза на хемоглобин - белтъкът в еритроцитите, който осигурява транспорта на кислород от белите дробове до всички тъкани в организма. При недостиг на желязо костният мозък не може да произвежда достатъчно количество хемоглобин, в резултат на което се образуват по-малки и по-слабо функциониращи червени кръвни клетки. Това състояние се нарича желязодефицитна анемия и е най-честата причина за намален брой еритроцити в световен мащаб. Дефицитът може да бъде причинен от недостатъчен прием на желязо с храната, нарушено усвояване (при заболявания като целиакия, гастрит или след оперативни интервенции на стомаха), повишени нужди по време на бременност или растеж, както и хронична кръвозагуба.
» Повече информация по темата: Желязодефицитна анемия
Дефицит на витамин Б12/фолиева киселина
Витамин B12 (кобаламин) и фолиевата киселина (витамин B9) играят съществена роля в процесите на клетъчно делене и синтез на ДНК. Те от своя страна са важни за съзряването на еритроцитите в костния мозък. При дефицит на някой от тези елементи производството на еритроцити се нарушава и се образуват по-големи, незрели клетки с неправилна структура, известни като мегалобласти. Това води до развитие на мегалобластна (пернициозна) анемия, характеризираща се с нисък брой еритроцити и нарушена функция. Освен симптомите на анемия, при недостиг на витамин B12 могат да се наблюдават и неврологични прояви като изтръпване, нарушения в походката и концентрацията.
» Повече информация по темата: Мегалобластна анемия
Кръвозагуба
Загубата на кръв е една от най-честите причини за намаляване на броя на еритроцитите. Тя може да бъде остра - вследствие на травма, операция, вътрешен кръвоизлив, или хронична - при стомашно-чревни заболявания (язвена болест, полипи, тумори), хемороиди, продължителни менструации и други. При остра кръвозагуба организмът първоначално компенсира с тахикардия (увеличен пулс), но при значителна загуба на кръв има опасност да се развие хиповолемичен шок. При хронична кръвозагуба запасите от желязо постепенно се изчерпват, което води до вторична желязодефицитна анемия.
Хемолитична анемия
Хемолитичната анемия се характеризира с преждевременно разрушаване на еритроцитите (хемолиза), което води до намаляване на техния брой и понижаване на хемоглобина. Обикновено животът на един еритроцит е средно около 120 дни, но при хемолитична анемия той се съкращава до няколко дни или седмици. Разрушаването на еритроцитите води до освобождаване на хемоглобин, който се метаболизира до билирубин, причинявайки характерен жълтеникав цвят на кожата и очите (иктер).
Хронична бъбречна недостатъчност
Бъбреците имат ключова роля в производството на еритроцити чрез секрецията на хормона еритропоетин. Този хормон стимулира костния мозък да създава нови червени кръвни клетки. При хронична бъбречна недостатъчност увредената бъбречна тъкан не произвежда достатъчно количество еритропоетин, което води до потискане на процеса еритропоеза и постепенно развитие на анемичен синдром.
» Повече информация по темата: Хронична бъбречна недостатъчност
Симптоми

Намаленият брой на еритроцити води до понижен транспорт на кислород до тъканите и органите, което нарушава нормалното им функциониране. Когато сатурацията на кръвта спадне под определено ниво, организмът реагира с компенсаторни механизми, които обаче често не са достатъчни. В резултат се развиват редица симптоми, свързани с нарушената оксигенация на тъканите.
- Обща отпадналост
- Лесна умора
- Бледа кожа и лигавици
- Недостиг на въздух
- Учестен пулс
- Световъртеж
- Главоболие
- Шум в ушите
- Студени крайници
- Нарушена концентрация
- Сънливост
- Жълтеникав оттенък на кожата и очите
- Болки в гърдите
Изследване и диагноза
Анамнеза
Събирането на информация за състоянието е първата стъпка в диагностиката. Лекарят разпитва за наличие на хронични заболявания, хранителни навици, прием на медикаменти, предходни кръвозагуби, излагане на токсични вещества, фамилна обремененост и наличие на симптоми като отпадналост, задух, умора или световъртеж.
Физикален преглед
При прегледа се оценява общото състояние на пациента и се търсят характерни признаци на анемия - бледа кожа и лигавици, тахикардия, тахипнея, увеличен черен дроб или слезка. Наблюдават се и промени по ноктите, косата и езика, които могат да насочат към конкретен тип анемия (желязодефицитна или мегалобластна).
Лабораторни изследвания
Основният диагностичен метод е пълната кръвна картина (ПКК), която показва броя на еритроцитите, нивата на хемоглобина и хематокрита. Извършват се и допълнителни тестове:
- Среден обем на еритроцитите (MCV) - за определяне на микро-, нормо- или макроцитна анемия.
- Средно съдържание на хемоглобин (MCH)
- Ретикулоцити (незрели еритроцити) - показват активността на костния мозък.
- Серумно желязо, феритин, витамин B12, фолиева киселина.
- Показатели за бъбречна и чернодробна функция.
- Кръвна натривка - оценка на формата и зрелостта на еритроцитите.
- Пункция на костен мозък (миелограма) - дава директна оценка на морфологията и наличието на патологични процеси в костния мозък.
Образни изследвания
При необходимост се извършват ултразвуково изследване на коремни органи за оценка на черен дроб, слезка и бъбреци. В някои случаи се назначава компютърна томография (КТ) или магнитен резонанс при съмнение за вътрешни кръвоизливи, тумори или друг вид патологични състояния.
Лечение

Лечението на намаления брой еритроцити зависи от основната причина и тежестта на състоянието. Основните терапевтични методи включват:
Заместващо лечение: При желязодефицитна анемия се назначава терапия с железни препарати. При дефицит на витамин B12 се прилагат инжекционни форми на кобаламин, а при липса на фолиева киселина се назначава орална суплементация. При анемия, свързана с хронични бъбречни заболявания, се използват препарати с еритропоетин, които стимулират производството на еритроцити в костния мозък.
Лечение на подлежащите заболявания: Контрол на хронични възпалителни процеси, автоимунни заболявания или онкологични състояния, които потискат еритропоезата.
Кръвопреливане: При тежка анемия, когато нивата на хемоглобина са силно понижени и има изразена симптоматика, се извършва кръвопреливане. Тази мярка е временна и се използва за бързо възстановяване на кислородния капацитет на кръвта.
Изображения: freepik.com
Продукти свързани със СИМПТОМА
БЪЗАК СИРОП 500 мл ЖИВИТА
БИОХЕРБА ЧАЙ ФИЛТЪР МАЩЕРКА * 20
ФЕРОГЛОБИН B12 сироп 200 мл ВИТАБИОТИКС
ФОРТЕФЕР саше * 30 ФОРТЕКС
ВИТАМИН B комплекс таблетки * 20 СОФАРМА
ЖЕЛЯЗО + МЕД + ВИТАМИНЕН КОМПЛЕКС капсули * 60
Библиография
https://my.clevelandclinic.org/health/body/21691-function-of-red-blood-cells
https://www.mayoclinic.org/diseases-conditions/anemia/symptoms-causes/syc-20351360
https://medlineplus.gov/ency/article/000560.htm
https://www.nhlbi.nih.gov/files/docs/public/blood/anemia-inbrief_yg.pdf
https://my.clevelandclinic.org/health/diseases/22824-iron-deficiency-anemia
https://www.nhs.uk/tests-and-treatments/red-blood-count/
https://www.hopkinsmedicine.org/health/conditions-and-diseases/hemolytic-anemia
Коментари към Намален брой на еритроцитите